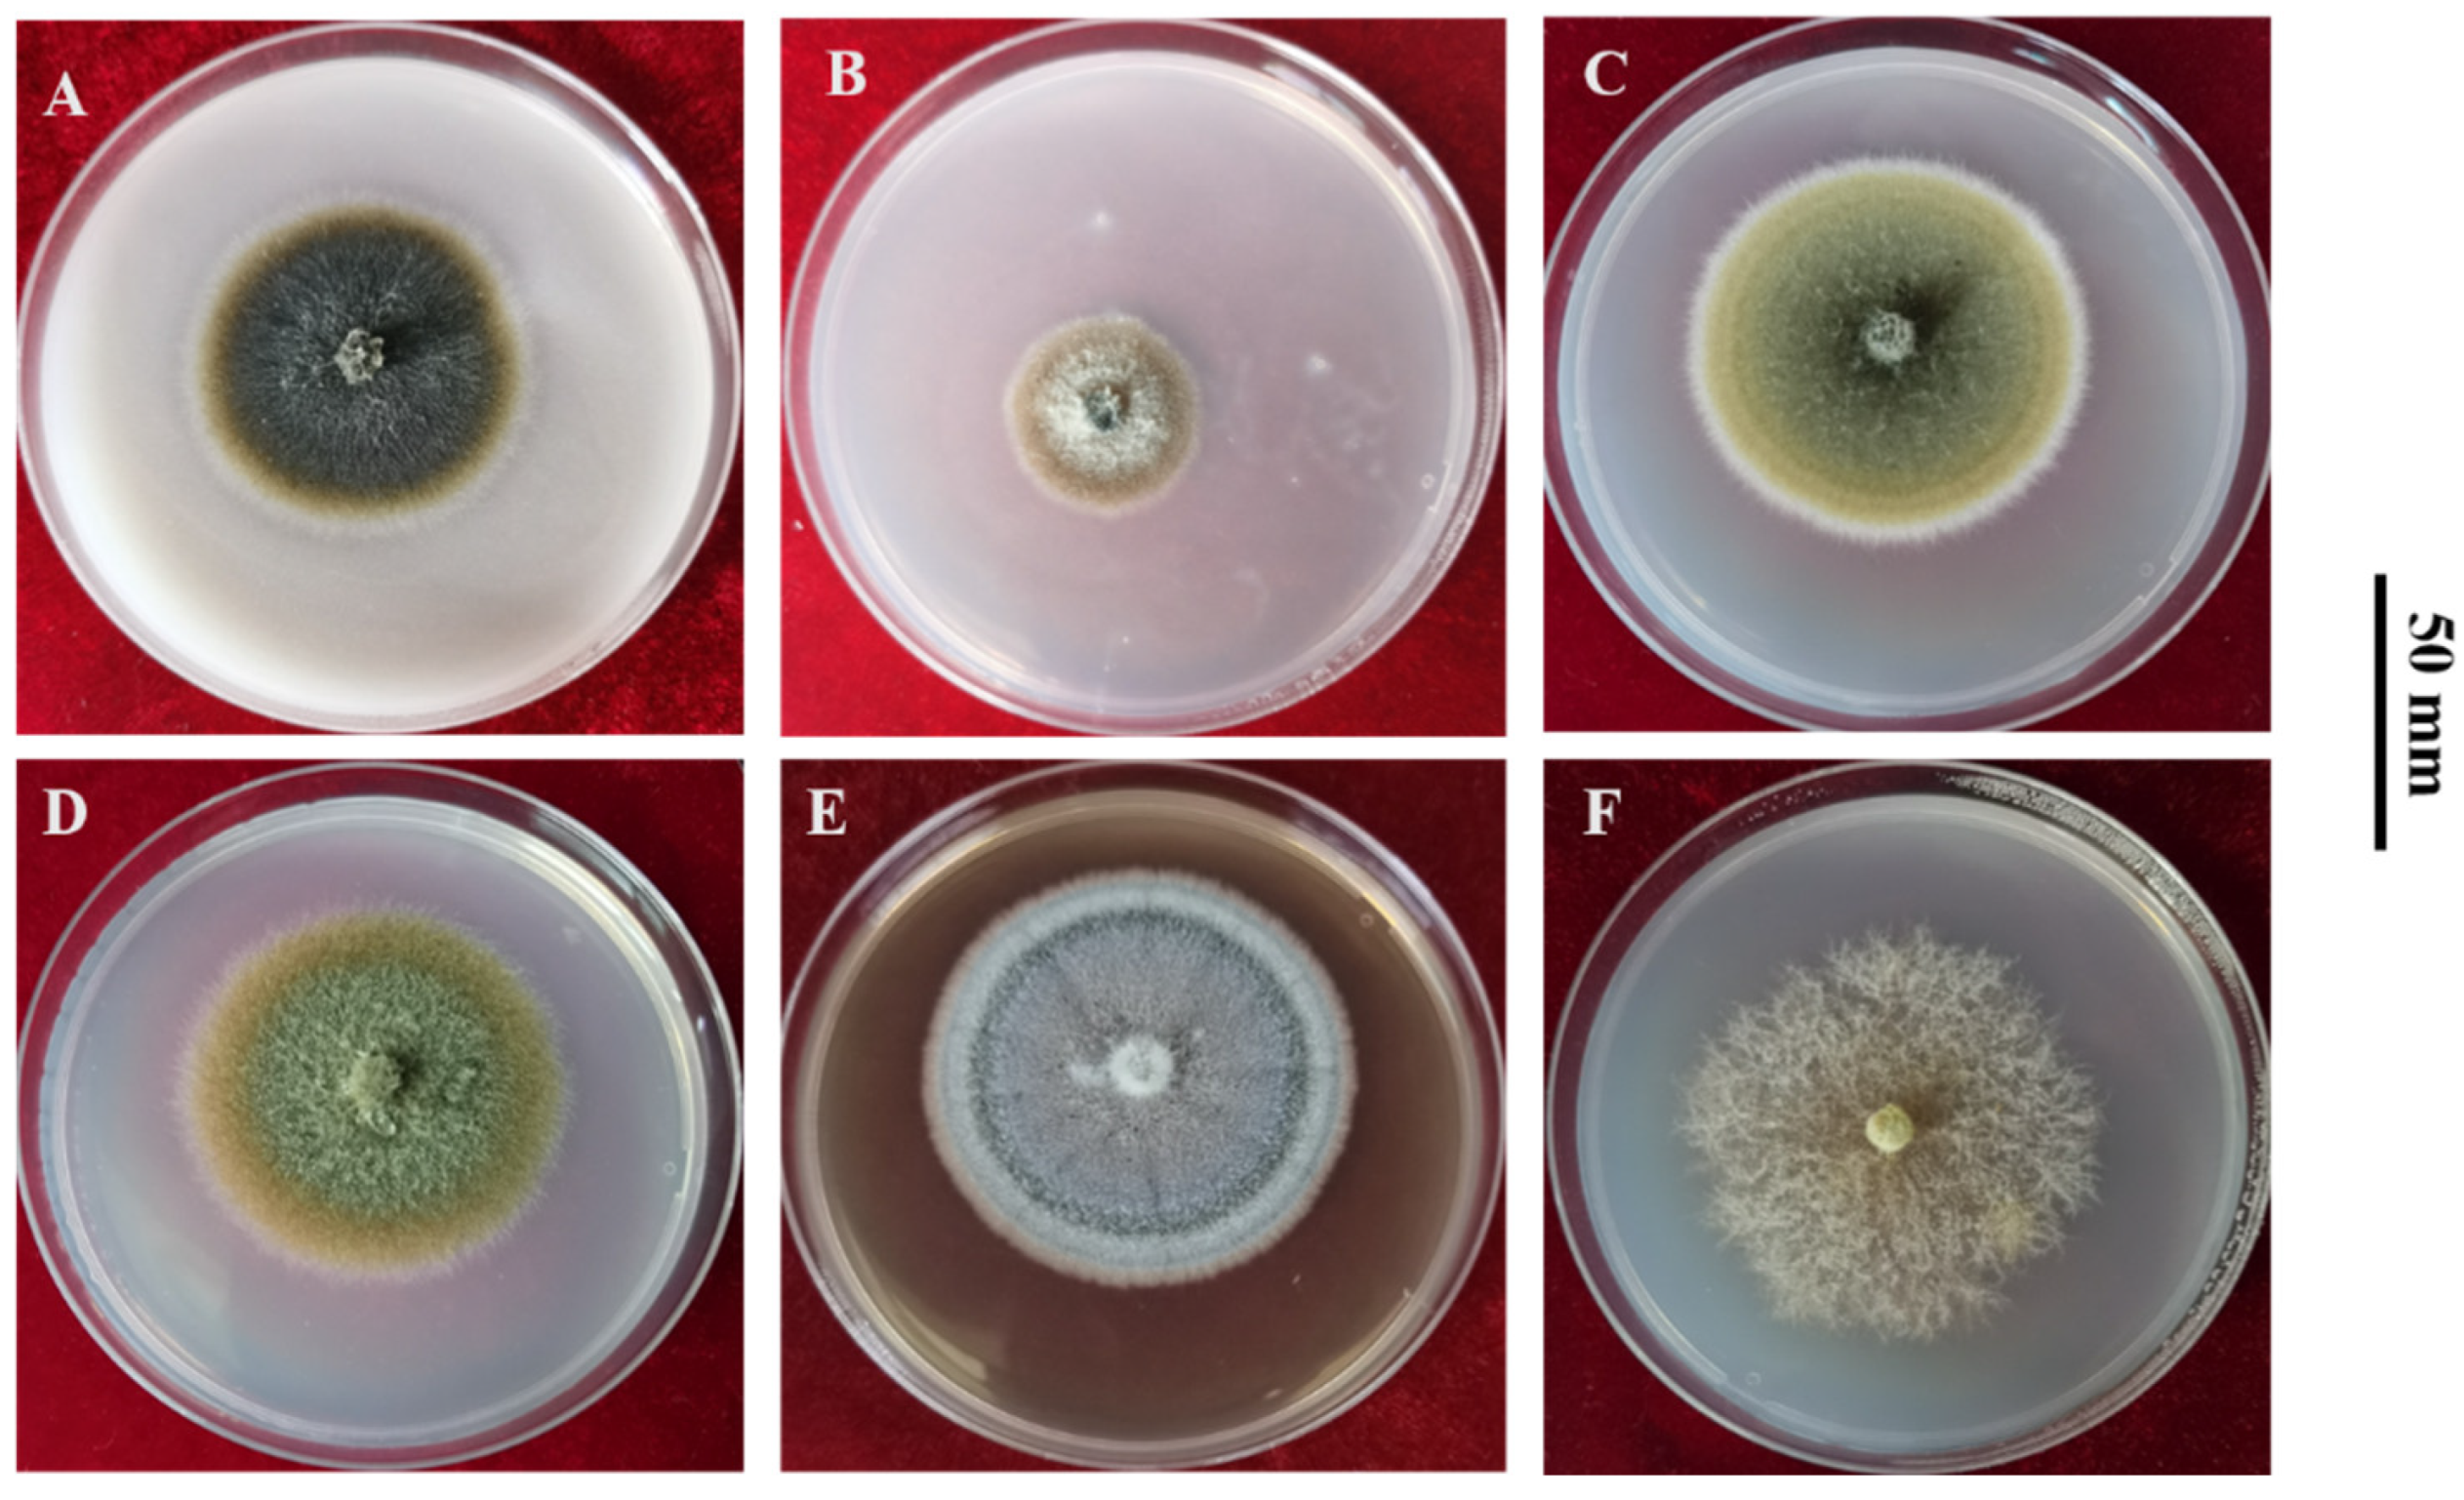
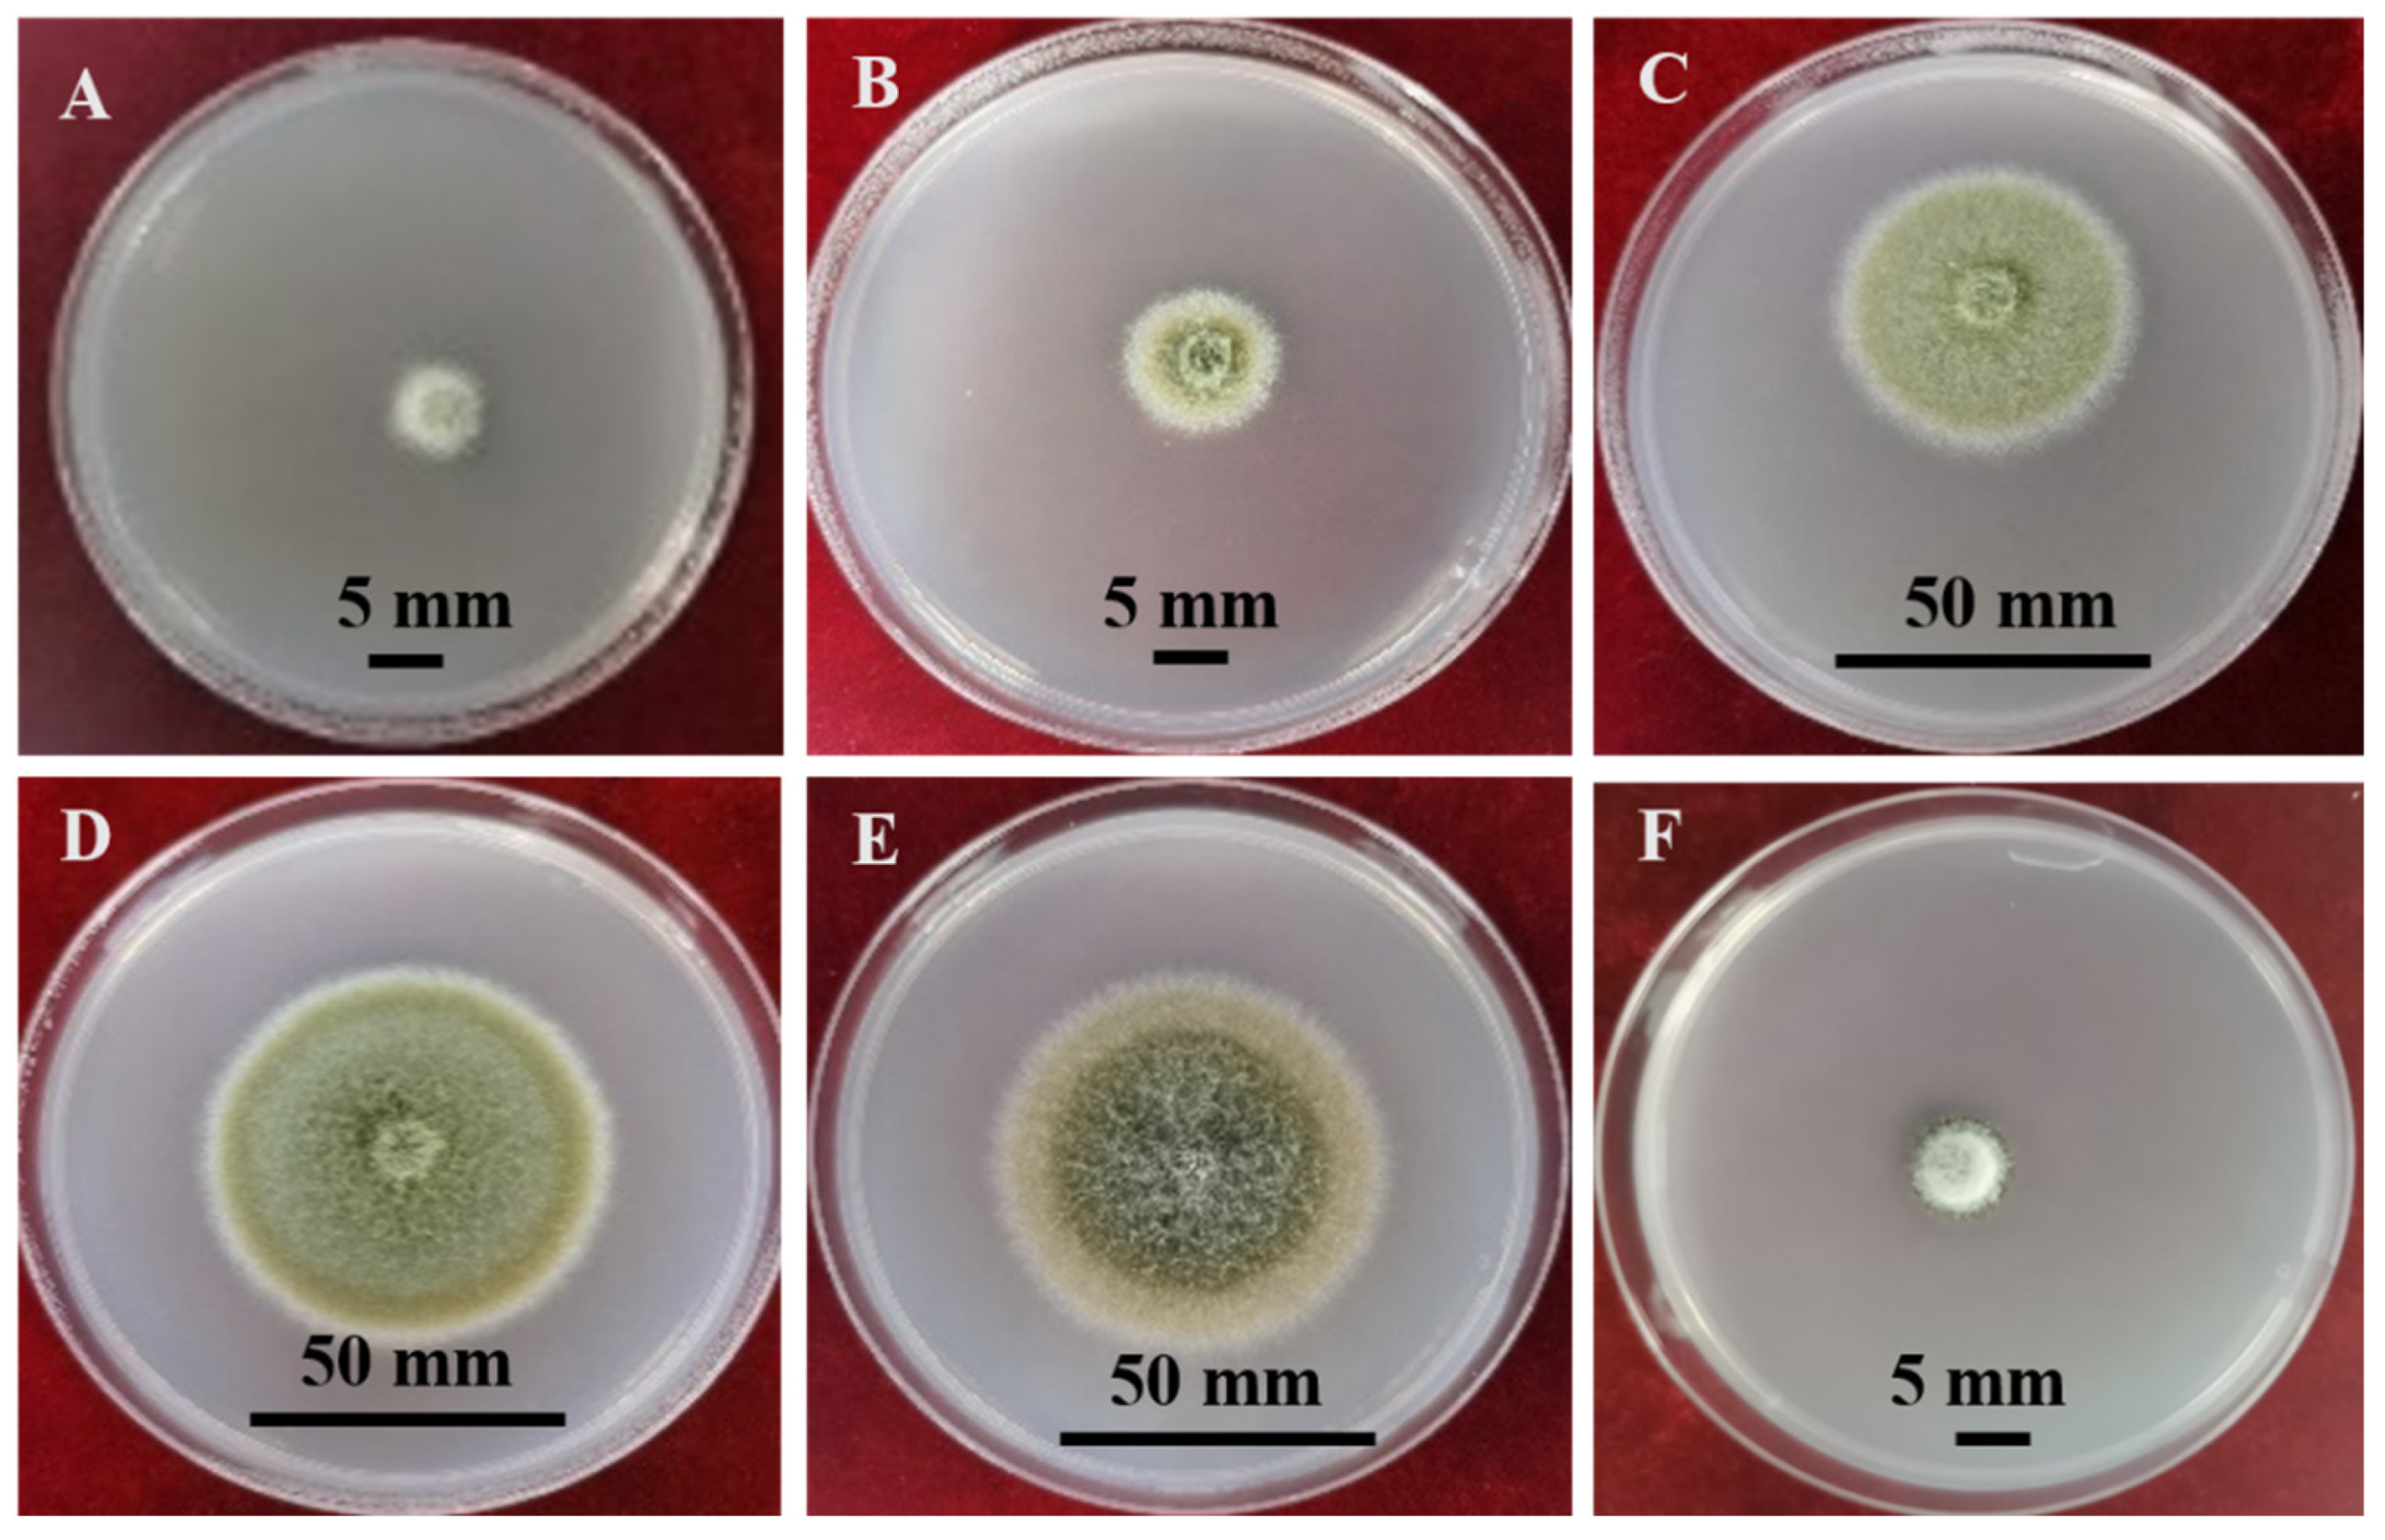

Alfalfa Spring Black Stem and Leaf Spot Disease Caused by Phoma medicaginis: Epidemic Occurrence and Impacts
Abstract
1. Introduction
2. The Pathogen
2.1. Classification
2.2. Culture Characteristics
3. Host Ranges of P. medicaginis
4. Symptoms in Infected Alfalfa Tissues
5. The Effect of P. medicaginis on Productivity of Alfalfa
6. Disease Epidemiology
6.1. Overwintering
6.2. Infection Process
6.3. Epidemiology of ASBS
7. Disease Assessment
8. Disease Control
8.1. Host Resistance—Induced Disease Resistance
8.2. Resistant Cultivars
8.3. Biological Control
8.4. Cultural Practice
8.5. Chemical Control
9. Concluding Perspectives
Supplementary Materials
Funding
Data Availability Statement
Conflicts of Interest
References
- Helaoui, S.; Boughattas, I.; Hattab, S.; Mkhinini, M.; Alphonse, V.; Livet, A.; Bousserrhine, N.; Banni, M. Physiological, biochemical and transcriptomic responses of Medicago sativa to Nickel exposure. Chemosphere 2020, 249, 126121. [Google Scholar] [CrossRef] [PubMed]
- Su, D.C.; Wong, J.W.C.; Jagadeesan, H. Implications of rhizospheric heavy metals and nutrients for the growth of alfalfa in sludge amended soil. Chemosphere 2004, 56, 957–965. [Google Scholar] [CrossRef] [PubMed]
- Chen, L.; Beiyuan, J.Z.; Hu, W.F.; Zhang, Z.Q.; Duan, C.J.; Cui, Q.L.; Zhu, X.Z.; He, H.R.; Huang, X.G.; Fang, L.C. Phytoremediation of potentially toxic elements (PTEs) contaminated soils using alfalfa (Medicago sativa L.): A comprehensive review. Chemosphere 2022, 293, 133577. [Google Scholar] [PubMed]
- Sun, B.; Peng, Y.; Yang, H.Y.; Li, Z.J.; Gao, Y.Z.; Wang, C.; Yan, Y.L.; Liu, Y.M. Alfalfa (Medicago sativa L.)/maize (Zea mays L.) intercropping provides a feasible way to improve yield and economic incomes in farming and pastoral areas of Northeast China. PLoS ONE 2014, 9, e110556. [Google Scholar] [CrossRef] [PubMed]
- Salehi Shanjani, P.; Salehi, P.; Jafari, A.A. Comparison of phenotypic trait variation and total protein polymorphism in local and exotic germplasms of Medicago sativa in Iran. N. Z. J. Agric. Res. 2013, 56, 142–155. [Google Scholar] [CrossRef]
- Mielmann, A. The utilisation of lucerne (Medicago sativa): A review. Br. Food J. 2013, 115, 590–600. [Google Scholar] [CrossRef]
- National Alfalfa and Forage Alliance. Available online: http://alfalfa.org/newsletter/180327nafanews.htm (accessed on 17 May 2024).
- Wang, Q.B.; Yang, Z. China’s alfalfa market and imports: Development, trends, and potential impacts of the U.S.-China trade dispute and retaliations. J. Integr. Agric. 2020, 19, 1149–1158. [Google Scholar] [CrossRef]
- Basigalup, D.H.; Ustarroz, E. Grazing alfalfa systems in the Argentinean Pampas. In Proceedings of the 37th California Alfalfa & Forage Symposium, Monterey, CA, USA, 17–19 December 2007. [Google Scholar]
- Statistics Canada. Table 004-0213—Census of Agriculture, Hay and Field Crops. Available online: http://www5.statcan.gc.ca/cansim/a47 (accessed on 9 May 2023).
- Tan, M.; Yolcu, H. Current status of forage crops cultivation and strategies for the future in Turkey: A Review. J. Agric. Sci-Tarim Bili. Derg. 2021, 27, 114–121. [Google Scholar] [CrossRef]
- Barbetti, M.J.; Riley, I.T.; You, M.P.; Li, H.; Sivasithamparam, K. The association of necrotrophic fungal pathogens and plant parasitic nematodes with the loss of productivity of annual medic-based pastures in Australia and options for their management. Australas. Plant Pathol. 2006, 35, 691–706. [Google Scholar] [CrossRef]
- Liu, R. Alfalfa Spring Black Stem Disease (Ring Spot). China Acad. J. Electron. Publ. House 1986. [Google Scholar] [CrossRef]
- Zhang, L.L.; Li, Y.Z. Occurrence and nutrition indicators of alfalfa with Leptosphaerulina in Chifeng, Inner Mongolia. Agriculture 2022, 12, 1465. [Google Scholar] [CrossRef]
- Barbetti, M.J.; Fang, C.S. Relationship between Phoma black stem severity and herbage and seed yield and coumestrol content in three Medicago polymorpha var. brevispina cultivars. Aust. J. Agric. Res. 1991, 42, 409–415. [Google Scholar] [CrossRef]
- Smith, J.F.; Jagusch, K.T.; Brunswick, L.F.C.; Kelly, R.W. Coumestans in lucerne and ovulation in ewes. N. Z. J. Agric. Res. 1979, 22, 411–416. [Google Scholar] [CrossRef]
- Tivoli, B.; Baranger, A.; Sivasithamparam, K.; Barbetti, M.J. Annual Medicago: From a model crop challenged by a spectrum of necrotrophic pathogens to a model plant to explore the nature of disease resistance. Ann. Bot. 2006, 98, 1117–1128. [Google Scholar] [CrossRef] [PubMed]
- Cormack, M.W. Studies on Ascochyta imperfecta, a seed- and soil-borne parasite of alfalfa. Phytopathology 1945, 35, 838–855. [Google Scholar]
- Mead, H.W. Infection of alfalfa seed by Ascochyta imperfecta Peck through the pod. Can. J. Bot. 1964, 42, 1101–1102. [Google Scholar] [CrossRef]
- Leath, K.T.; Erwin, D.C.; Griffin, G.D. Diseases and nematodes. In Alfalfa and Alfalfa Improvement; Hanson, A.A., Barnes, D.K., Hill, R.R., Eds.; American Society of Agronomy: Madison, WI, USA, 1988; pp. 621–670. [Google Scholar]
- Chen, Q.; Jiang, J.R.; Zhang, G.Z.; Cai, L.; Crous, P.W. Resolving the Phoma enigma. Stud. Mycol. 2015, 82, 137–217. [Google Scholar] [CrossRef]
- Boerema, G.H.; De Gruyter, J.; Noordeloos, M.E.; Hamers, M.E.C. Phoma identification manual. In Differentiation of Specific and Infraspecific Taxa in Culture; CABI Publishing: Oxfordshire, UK, 2004; pp. 1–21. [Google Scholar]
- De Gruyter, J.; Aveskamp, M.M.; Woudenberg, J.H.C.; Verkley, G.J.M.; Groenewald, J.Z.; Crous, P.W. Molecular phylogeny of Phoma and allied anamorph genera: Towards a reclassification of the Phoma complex. Mycol. Res. 2009, 113, 508–519. [Google Scholar] [CrossRef]
- Stewart, F.C.; French, G.T.; Wilson, J.K. Bulletin: Number 305: Troubles of Alfalfa in New York. N.Y. (Geneva) Agricultural Experiment Station. 1908. Available online: https://ecommons.cornell.edu/items/14502634-24de-4ff5-a668-68acc594787a (accessed on 9 May 2023).
- Boerema, G.H.; Dorenbosch, M.M.J.; Leffring, L. A comparative study of the black stem fungi on lucerne and red clover and the footrot fungus on pea. Neth. J. Plant Pathol. 1965, 71, 79–89. [Google Scholar] [CrossRef]
- Wang, H.; Hwang, S.F.; Chang, K.F.; Gossen, B.D.; Turnbull, G.D.; Howard, R.J. Assessing resistance to spring black stem and leaf spot of alfalfa caused by Phoma spp. Can. J. Plant Sci. 2004, 84, 311–317. [Google Scholar] [CrossRef]
- Edmunds, L.K.; Hanson, E.W. Host range, pathogenicity, and taxonomy of Ascochyta imperfecta. Phytopathology 1960, 50, 105–108. [Google Scholar]
- De Gruyter, J.; Boerema, G.H.; van der Aa, H.A. Contributions towards a monograph of Phoma (Coelomycetes) VI—2. Section Phyllostictoides: Outline of its taxa. Persoonia 2002, 18, 1–53. [Google Scholar]
- Zhang, L.; Pan, L.Q.; Wang, S.R.; Yuan, Q.H.; Wang, Y.; Miao, L.H. Study on the biological characteristics of the alfalfa Phoma leaf spot pathogen. J. China Agric. Univ. 2015, 20, 158–166. [Google Scholar]
- Mead, H.W. Studies on Ascochyta imperfecta Peck. factors affecting sporulation of Canadian isolates on natural and artificial media. Can. J. Bot. 1962, 40, 263–271. [Google Scholar] [CrossRef]
- Chung, H.S.; Wilcoxson, R.D. Effects of temperature, light, carbon and nitrogen nutrition on reproduction in Phoma medicaginis. Mycopathol. Mycol. Appl. 1971, 44, 297–308. [Google Scholar] [CrossRef] [PubMed]
- Noordeloos, M.E.; De Gruyter, J.; Van Eijk, G.W.; Roeijmans, H.J. Production of dendritic crystals in pure cultures of Phoma and Ascochyta and its value as a taxonomic character relative to morphology, pathology and cultural characteristics. Mycol. Res. 1993, 97, 1343–1350. [Google Scholar] [CrossRef]
- Weber, R.W.S.; Stenger, E.; Meffert, A.; Hahn, M. Brefeldin A production by Phoma medicaginis in dead pre-colonized plant tissue: A strategy for habitat conquest? Mycol. Res. 2004, 108, 662–671. [Google Scholar] [CrossRef] [PubMed]
- Sprague, R. Host range and life-history studies of some leguminous Ascochytae. Phytopathology 1929, 19, 917. [Google Scholar]
- Mead, H.W.; Cormack, M.W. Studies on Ascochyta imperfecta Peck: Parasitic strains among fifty isolates from Canadian alfalfa seed. Can. J. Bot. 1961, 9, 793–797. [Google Scholar] [CrossRef]
- Jayasiri, S.C.; Hyde, K.D.; Jones, E.B.G.; Jeewon, R.; Ariyawansa, H.A.; Bhat, J.D.; Camporesi, E.; Kang, J.C. Taxonomy and multigene phylogenetic evaluation of novel species in Boeremia and Epicoccum with new records of Ascochyta and Didymella (Didymellaceae). Mycosphere 2017, 8, 1080–1101. [Google Scholar] [CrossRef]
- Kowalik, M.; Sagan, A. Fungi causing dying out of heather in permanent plantings. Acta Mycol. 2005, 40, 191–195. [Google Scholar] [CrossRef][Green Version]
- Kowalik, M.; Bonio, J.; Duda-Franiak, K. Micromycetes on ericaceous plant leaves. Acta Mycol. 2015, 50, 1055. [Google Scholar] [CrossRef][Green Version]
- Ellwood, S.R.; Kamphuis, L.G.; Oliver, R.P. Identification of sources of resistance to Phoma medicaginis isolates in Medicago truncatula SARDI core collection accessions, and multigene differentiation of isolates. Phytopathology 2006, 96, 1330–1336. [Google Scholar] [CrossRef] [PubMed]
- Castell-Miller, C.V.; Zeyen, R.J.; Samac, D.A. Infection and development of Phoma medicaginis on moderately resistant and susceptible alfalfa genotypes. Can. J. Plant Pathol. 2007, 29, 290–298. [Google Scholar] [CrossRef]
- Djebali, N. Aggressiveness and host range of Phoma medicaginis isolated from Medicago species growing in Tunisia. Phytopathol. Mediterr. 2013, 52, 3–15. [Google Scholar]
- Barbetti, M.J. Effects of temperature and humidity on disease caused by Phoma medicaginis, resistance in some Medicago cultivars and the incidence of seed-borne inoculum. Aust. J. Exp. Agric. 1987, 27, 851–856. [Google Scholar] [CrossRef]
- Gray, F.A.; Fernandez, J.A.; Horton, J.L. Variation among isolates of Phoma medicaginis var. medicaginis in spore production in vitro and symptom expression on excised leaves of alfalfa. Plant Dis. 1990, 74, 668–670. [Google Scholar]
- Rhodes, L.H.; Myers, D.K. Severity of spring black stem on alfalfa cultivars in Ohio. Plant Dis. 1986, 70, 746–748. [Google Scholar] [CrossRef]
- Rodríguez, R.D.P. Comparative variation of Phoma medicaginis Malbr. Roum. var. medicaginis Boerema for cultural characteristics and virulence to roots and crowns of alfalfa. J. Agric. Univ. Puerto Rico 2005a, 89, 229–242. [Google Scholar]
- Rodriguez, R.; Leath, K.T. Pathogenicity of Phoma medicaginis var. medicaginis to crowns of alfalfa. Plant Dis. 1992, 76, 1237–1240. [Google Scholar] [CrossRef]
- Rodriguez, R.; Leath, K.T.; Hill, R.R. Pathogenicity of Phoma medicaginis var. medicaginis to roots of alfalfa. Plant Dis. 1990, 74, 680–683. [Google Scholar]
- Mead, H.W. Studies on Ascochyta imperfecta Peck. differential utilization of nutrients by isolates from Canadian alfalfa seed. Can. J. Bot. 1961, 39, 1591–1594. [Google Scholar] [CrossRef]
- Vonchong, K.; Campbell, C.L. Seasonal occurrence of leaf-spot pathogens of alfalfa in North-Carolina. Plant Dis. 1988, 72, 667–672. [Google Scholar]
- Olah, A.F. Flavones, isoflavones, and coumestans in alfalfa infected by Ascochyta imperfecta. Phytopathology 1971, 61, 65. [Google Scholar] [CrossRef]
- Hijano, E.H. Effect of spring black stem on yield and growth of alfalfa in the greenhouse. Plant Dis. 1981, 65, 725–726. [Google Scholar] [CrossRef]
- Akamatsu, H.O.; Chilvers, M.I.; Peever, T.L. First report of spring black stem and leaf spot of alfalfa in Washington State caused by Phoma medicaginis. Plant Dis. 2008, 92, 833. [Google Scholar] [CrossRef] [PubMed]
- Barbetti, M.J. Fungal foliage diseases of pasture legumes. J. Agric. West. Aust. 1983, 24, 10–12. [Google Scholar]
- Hwang, S.F.; Wang, H.; Gossen, B.D.; Chang, K.F.; Turnbull, G.D.; Howard, R.J. Impact of foliar diseases on photosynthesis, protein content and seed yield of alfalfa and efficacy of fungicide application. Eur. J. Plant Pathol. 2006, 115, 389–399. [Google Scholar] [CrossRef]
- Nan, Z.B.; Li, C.J.; Wang, Y.W.; Wang, Y.R. Lucerne common leaf spot: Forage quality, photosynthesis rate and field resistance. Acta Prataculturae Sin. 2001, 10, 26–34. [Google Scholar]
- Fields, R.L.; Barrell, G.K.; Gash, A.; Zhao, J.; Moot, D.J. Alfalfa coumestrol content in response to development stage, fungi, aphids, and cultivar. Crop Ecol. Physiol. 2018, 110, 910–921. [Google Scholar] [CrossRef]
- Omidvari, M.; Flematti, G.R.; You, M.P.; Abbaszadeh-Dahaji, P.; Barbetti, M.J. Phoma medicaginis isolate differences determine disease severity and phytoestrogen production in annual Medicago spp. Plant Dis. 2021, 105, 2849–2858. [Google Scholar] [CrossRef] [PubMed]
- Omidvari, M.; Flematti, G.R.; You, M.P.; Abbaszadeh-Dahaji, P.; Barbetti, M.J. Plant growth stage and Phoma medicaginis inoculum con centration together determine severity of Phoma black stem and leaf spot and consequent phytoestrogen production in annual Medicago spp. Plant Pathol. 2023, 72, 1463–1475. [Google Scholar] [CrossRef]
- Seguin, P.; Zheng, W.; Souleimanov, A. Alfalfa phytoestrogen content: Impact of plant maturity and herbage components. J. Agron. Crop Sci. 2004, 190, 211–217. [Google Scholar] [CrossRef]
- Kernkamp, M.F.; Hemerick, G.A. The relation of Ascochyta imperfecta to alfalfa seed production in Minnesota. Phytopathology 1953, 43, 378. [Google Scholar]
- Truszkowska, W.; Legie, B. The influence of host residues on the occurrence of some fungal diseases of red clover and alfalfa. Acta Mycol. 1973, 9, 53–66. [Google Scholar] [CrossRef][Green Version]
- Rodríguez, R.D.P. Histological studies on the development of Phoma root rot of alfalfa. J. Agric. Univ. Puerto Rico 2005b, 89, 251–262. [Google Scholar]
- Barbetti, M.J. Effects of temperature and humidity on diseases caused by Phoma medicaginis and Leptosphaerulina trifolii in lucerne (Medicago sativa). Plant Pathol. 1991, 40, 296–301. [Google Scholar] [CrossRef]
- Mead, H.W. Comparison of temperatures favoring growth of Ascochyta imperfecta Peck and development of spring black stem on alfalfa in Saskatchewan. Can. J. Bot. 1963, 41, 312–314. [Google Scholar] [CrossRef]
- Rizvi, S.S.A.; Nutter, F.W. Seasonal dynamics of alfalfa foliar pathogens in Iowa. Plant Dis. 1993, 77, 1126–1135. [Google Scholar] [CrossRef]
- Naseri, B.; Marefat, A.R. Seasonal dynamics and prevalence of alfalfa fungal pathogens in Zanjan province, Iran. Int. J. Plant Prod. 2008, 2, 1735–6814. [Google Scholar]
- Blakeman, J.P.; Dickinson, C.H. The effect of ultraviolet and visible light on infection of host leaf tissue by four species of Ascochyta. Trans. Brit. Mycol. Soc. 1967, 50, 385–396. [Google Scholar] [CrossRef]
- Nutter, F.W.; Guan, J., Jr.; Gotlieb, A.R.; Rhodes, L.H.; Grau, C.R.; Sulc, R.M. Quantifying alfalfa yield losses caused by foliar diseases in Iowa, Ohio, Wisconsin, and Vermont. Plant Dis. 2002, 86, 269–277. [Google Scholar] [CrossRef]
- Nilsson, H.E. Remote sensing and image analysis in plant pathology. Annu. Rev. Phytopathol. 1995, 33, 489–527. [Google Scholar] [CrossRef]
- Guan, J.; Nutter, F.W., Jr. Comparison of single-point alfalfa yield models based on visual disease intensity and remote sensing assessments. Can. J. Plant Pathol. 2004, 26, 314–324. [Google Scholar] [CrossRef]
- Mattupalli, C.; Moffet, C.A.; Shah, K.N.; Young, C.A. Supervised classification of RGB aerial imagery to evaluate the impact of a root rot disease. Remote Sens. 2018, 10, 917. [Google Scholar] [CrossRef]
- Abd-Elmagid, A.; Garrido, P.A.; Hunger, R.; Lyles, J.L.; Mansfield, M.A.; Gugino, B.K.; Smith, D.L.; Melouk, H.A.; Garzon, C.D. Discriminatory simplex and multiplex PCR for four species of the genus Sclerotinia. J. Microbiol. Meth. 2013, 92, 293–300. [Google Scholar] [CrossRef] [PubMed]
- Arif, M.; Fletcher, J.; Marek, S.M.; Melcher, U.; Ochoa-Corona, F.M. Development of a rapid, sensitive, and field-deployable razor ex biodetection system and quantitative PCR assay for detection of Phymatotrichopsis omnivora using multiple gene targets. Appl. Environ. Microbiol. 2013, 79, 2312–2320. [Google Scholar] [CrossRef]
- Larsen, R.C.; Hollingsworth, C.R.; Vandemark, G.J.; Gritsenko, M.A.; Gray, F.A. A rapid method using PCR-based SCAR markers for the detection and identification of Phoma sclerotioides: The cause of brown root rot disease of alfalfa. Plant Dis. 2002, 86, 928–932. [Google Scholar] [CrossRef] [PubMed][Green Version]
- Dang, S.Z.; Cao, S.; Hu, J.L.; Li, Y.Z. Specific primers of Paraphoma radicina which causes alfalfa Paraphoma root rot. Eur. J. Plant Pathol. 2022, 162, 489–499. [Google Scholar] [CrossRef]
- Terry, L.A.; Joyce, D.C. Elicitors of induced disease resistance in postharvest horticultural crops: A brief review. Postharvest Biol. Tec. 2004, 32, 1–13. [Google Scholar] [CrossRef]
- Bahramnejad, B.; Goodwin, P.H.; Zhang, J.; Atnaseo, C.; Erickson, L.R. A comparison of two class 10 pathogenesis-related genes from alfalfa and their activation by multiple stresses and stress-related signaling molecules. Plant Cell Rep. 2010, 29, 1235–1250. [Google Scholar] [CrossRef] [PubMed]
- Li, Y.D.; Duan, T.Y.; Nan, Z.B.; Li, Y.Z. Arbuscular mycorrhizal fungus alleviates alfalfa leaf spots caused by Phoma medicaginis revealed by RNA-seq analysis. J. Appl. Microbiol. 2021, 130, 547–560. [Google Scholar] [CrossRef] [PubMed]
- Xu, L.B.; Liu, Z.P.; Wang, H.X.; Yang, H.Q.; Ulan, B. The induction effect of jasmonic acid on alfalfa disease resistance. Chin. J. Grassl. 2013, 35, 57–61. [Google Scholar]
- Salter, R.M.; Leath, K.L. Spring Black Stem and Leafspot Resistance. Section D-11 in: Standard Tests to Characterize Alfalfa Cultivars. 1991, Volume 3. Available online: https://api.semanticscholar.org/CorpusID:85897390 (accessed on 9 May 2023).
- O’Neill, N.R.; Bauchan, G.R.; Samac, D.A. Reactions in the annual Medicago spp. core germ plasm collection to Phoma medicaginis. Plant Dis. 2003, 87, 557–562. [Google Scholar] [CrossRef] [PubMed]
- Omidvari, M.; Flematti, G.R.; You, M.P.; Abbaszadeh-Dahaji, P.; Barbetti, M.J. Phoma black stem severity and phytoestrogen production in annual Medicago spp. is primarily determined by interaction of cultivar and pathogen isolate. Plant Pathol. 2022, 71, 860–872. [Google Scholar] [CrossRef]
- Badri, M.; Ayadi, A.; Mahjoub, A.; Benltoufa, A.; Chaouachi, M.; Ranouch, R.; Ben Cheikh, N.; Abdelguerfi, A.; Laouar, M.; Abdelly, C.; et al. Variability in responses to Phoma medicaginis infection in a Tunisian collection of three annual Medicago species. Plant Pathol. J. 2023, 39, 171–180. [Google Scholar] [CrossRef] [PubMed]
- Barbetti, M.J. Resistance in annual Medicago spp. to Phoma medicaginis and Leptosphaerulina trifolii and its relationship to induced production of a phytoestrogen. Plant Dis. 2007, 91, 239–244. [Google Scholar] [CrossRef]
- Botkin, J.R.; Farmer, A.D.; Young, N.D.; Curtin, S.J. Genome assembly of Medicago truncatula accession SA27063 provides insight into spring black stem and leaf spot disease resistance. BMC Genom. 2024, 25, 204. [Google Scholar] [CrossRef]
- Paiva, N.L.; Oommen, A.; Harrison, M.J.; Dixon, R.A. Regulation of isoflavonoid metabolism in alfalfa. Plant Cell Tiss. Org. 1994, 38, 213–220. [Google Scholar] [CrossRef]
- Liatukiene, A.; Liatukas, Z.; Ruzgas, V. Reaction of the Lithuanian alfalfa breeding populations to Phoma medicaginis under cool temperate climate conditions. Pak. J. Bot. 2015, 47, 919–925. [Google Scholar]
- Samac, D.A.; Willert, A.M.; Mcbride, M.J.; Kinkel, L.L. Effects of antibiotic-producing Streptomyces on nodulation and leaf spot in alfalfa. Appl. Soil Ecol. 2003, 22, 55–66. [Google Scholar] [CrossRef]
- Gao, P.; Li, Y.D.; Guo, Y.E.; Duan, T.Y. Co-inoculation of lucerne (Medicago sativa) with an AM fungus and a rhizobium reduces occurrence of spring black stem and leaf spot caused by Phoma medicaginis. Crop Pasture Sci. 2018, 69, 933–943. [Google Scholar] [CrossRef]
- Wang, Y.J.; Li, Y.D.; Duan, T.Y. Arbuscular mycorrhizal fungus changes alfalfa response to pathogen infection activated by pea aphid infestation. Front. Microbiol. 2023, 13, 1074592. [Google Scholar] [CrossRef] [PubMed]
- Slimene, I.B.; Tabbene, O.; Gharbi, D.; Mnasri, B.; Schmitter, J.M.; Urdaci, M.C.; Limam, F. Isolation of a chitinolytic Bacillus licheniformis S213 strain exerting a biological control against Phoma medicaginis infection. Appl. Biochem. Biotech. 2015, 175, 3494–3506. [Google Scholar] [CrossRef] [PubMed]
- Rosier, A.; Pomerleau, M.; Beauregard, P.B.; Samac, D.A.; Bais, H.P. Surfactin and SPO0A-dependent antagonism by Bacillus subtilis strain UD1022 against Medicago sativa phytopathogens. Plants 2023, 12, 1007. [Google Scholar] [CrossRef]
- Li, Y.D.; Nan, Z.B.; Matthew, C.; Wang, Y.J.; Duan, T.Y. Arbuscular mycorrhizal fungus changes alfalfa (Medicago sativa) metabolites in response to leaf spot (Phoma medicaginis) infection, with subsequent effects on pea aphid (Acyrthosiphon pisum) behavior. New Phytol. 2023, 239, 286–300. [Google Scholar] [CrossRef] [PubMed]
- Mrabet, M.; Abdellatif, E.; Zribi, K.; Mhamdi, R.; Djebali, N. Sinorhizobium meliloti can protect Medicago truncatula from infection by Phoma medicaginis. Phytopathol. Mediterr. 2011, 50, 183–191. [Google Scholar]
- Slimene, I.B.; Tabbene, O.; Djebali, N.; Cosette, P.; Schmitter, J.M.; Jouenne, T.; Urdaci, M.C.; Limam, F. Putative use of a Bacillus subtilis L194 strain for biocontrol of Phoma medicaginis in Medicago truncatula seedlings. Res. Microbiol. 2012, 163, 388–397. [Google Scholar] [CrossRef]
- Chen, J.X.; Cai, R.; Tang, L.; Wang, D.; Lv, R.; Guo, C.H. Antagonistic activity and mechanism of Bacillus subtilis CG-6 suppression of root rot and growth promotion in Alfalfa. Microb. Pathog. 2024, 190, 106616. [Google Scholar] [CrossRef]
- Hu, J.L.; Zheng, M.Z.; Dang, S.Z.; Shi, M.; Li, Y.Z. Biocontrol potential of Bacillus amyloliquefaciens LYZ69 against anthracnose of alfalfa (Medicago sativa L.). Phytopathology 2021, 111, 1338–1348. [Google Scholar] [CrossRef]
- Kentelky, E.; Szekely-Varga, Z. Impact of foliar fertilization on growth, flowering, and corms production of five Gladiolus varieties. Plants 2021, 10, 1963. [Google Scholar] [CrossRef] [PubMed]
- Cotuna, O.; Micu, L.; Sărăţeanu, V.; Damianov, S.; Petanec, D. Researches regarding foliar and organic fertilizers influences on pathogenesis of Ascochyta imperfecta Peck fungus, under the weather conditions of Banat field. Lucr. Ştiinţifice Ser. Agron. 2010, 53, 174–178. [Google Scholar]
- Gilbert, R.G. Burning to reduce sclerotia of Sclerotinia sclerotiorum in alfalfa seed fields of southeastern Washington. Plant Dis. 1991, 75, 141–142. [Google Scholar] [CrossRef]
- Wiggins, B.E.; Kinkel, L.L. Green manures and crop sequences influence alfalfa root rot and pathogen inhibitory activity among soil-borne Streptomycetes. Plant Soil 2005, 268, 271–283. [Google Scholar] [CrossRef]
- Wang, H.; Hwang, S.F.; Chang, K.F.; Turnbull, G.D.; Howard, R.J. Pathogenic variation of Phoma spp. from alfalfa and chemical control of Phoma pathogens in Alberta. In Proceedings of the Annual Meeting of the American Phytopathological Society, Milwaukee, WI, USA, 27–31 July 2002. [Google Scholar]
- Broscious, S.C.; Kirby, H.W. Economic evaluation of fungicides for control of alfalfa foliar diseases. Phytopathology 1988, 78, 934–939. [Google Scholar] [CrossRef]
- Samac, D.A.; Foster-Hartnett, D. Effect of glyphosate application on foliar diseases in glyphosate-tolerant alfalfa. Plant Dis. 2012, 96, 1104–1110. [Google Scholar] [CrossRef] [PubMed][Green Version]
- Campbell, C.L.; Duthie, J.A. Impact of leaf spot diseases on yield and quality of alfalfa in North Carolina. Plant Dis. 1990, 74, 241–245. [Google Scholar] [CrossRef]
- Willis, W.G.; Stuteville, D.L.; Sorensen, E.L. Effects of leaf and stem diseases on yield and quality of alfalfa forage. Crop Sci. 1969, 9, 637–640. [Google Scholar] [CrossRef]
- Fewell, A.M.; Roddick, J.G.; Weissenberg, M. Interactions between the glycoalkaloids solasonine and solamargine in relation to inhibition of fungal growth. Phytochemistry 1994, 37, 1007–1011. [Google Scholar] [CrossRef]
- Matheron, M.E.; Matejka, J.C. Field crops reports: Alfalfa. Fungic. Nematic. Tests 1987, 44, 169. [Google Scholar]
- Matheron, M.E.; Matejka, J.C. Cereal and forage reports: Alfalfa. Fungic. Nematic. Tests 1988, 45, 168. [Google Scholar]
- Lengkeek, V.H. Field and cereal cropdisease reports: Alfalfa. Fungic. Nematic. Tests 1980, 36, 83. [Google Scholar]

| Country | Plant Tissue Isolated From | Inoculated Tisues | Inoculation Method | Symptom(s) | Reference(s) |
|---|---|---|---|---|---|
| Canada | Seeds | Excised leaves | Spraying spore suspension | Lesion | [35] |
| - | - | Pods, peduncles | Spraying homogenized agar cultures of P. medicaginis | Lesion | [20] |
| Netherlands, USA and Canada | Seeds, stems, leaves | Roots and detached leaves | Roots: dipping in a spore suspension; Detached leaves: spraying with spore suspension | Roots: yellow lower leaves and brownish-black stems and roots; leaves: leaf spot | [25] |
| - | - | Leaves | Spraying spore suspension | Slight chlorosis appeared 3 days after inoculation, and typical black leafspots formed by the 6th day. | [50] |
| USA | - | Leaves and stems | Stems: spraying spore suspension at 2.5 × 107 spores/mL after rubbing with silicon carbide; Leaves: spraying spore suspension at 2.5 × 105 spores/mL | Foliar and stem lesions | [51] |
| USA | - | Leaves and stems | Spraying spore suspension at 2 × 106 spores/mL | Foliar and stem lesions | [44] |
| - | M. truncatula | Leaves, stems and petioles | Spraying spore suspension at 7.0 × 106 spores/mL | Leaf lesions; petioles collapsed | [42] |
| USA | Seeds | Excised leaves and petioles | Sprayed with a spore suspension three times at 24 h intervals | Leaf spot, chlorosis; petiole blight (darkening and necrosis); petioles were affected more than leaves | [43] |
| USA and England | Roots | Roots | Gnotobiotic culture: the spore suspension was pipetted into a vertical hole in the agar near the plant roots, which were growing rooted in tubes with agar. Slant-board culture: Pieces of alfalfa stem colonized with P. medicaginis were placed in contact with roots, which were spread fanlike in the slant culture board; Greenhouse culture: wounded and nonwounded roots were respectively immersed for 1 h in a spore suspension of 2 × 106 spores/mL | Gnotobiotic culture: blackish, dry necrosis and tissue collapse were observed at or around the infection site. Withering, wilting, chlorosis, and reddening of foliage occurred on plants with severely diseased roots. Slant-board culture: Roots were often collapsed, with necrosis extending above and below the inoculation site. Greenhouse culture: necrosis occurred, especially on lateral roots. | [47] |
| USA | Crown | Crown of seedling and old plant, and stubble | Slant-board culture: placing an infested cloth square or applying spores with P. medicaginis to the surfaces of wounded crowns Greenhouse culture: crown was inoculated by using the infested needle technique; stubble inoculation with a toothpick infested with a mass of conidia | Crowns: intact crowns produced no rot symptoms; wounded crowns produced stub dieback and necrosis around wound site in slant-board and greenhouse culture. Stubble: black necrosis was observed initially; necrosis advanced down the stub, and stopped at the next node | [46] |
| Canada | Leaves | Leaves | 5 mm mycelial disks were placed on detached leaves | Mean lesion size on detached leaves of 18 alfalfa cultivars 8 d after inoculation ranged from 2.5–8.2 mm in diameter | [26] |
| Germany | Asymptomatic leaves, petioles and stems | Leaves | Spraying spore suspension | Larger lesions and confined necrotic spots appeared on leaves within 2 weeks of spray-inoculation | [33] |
| England and USA | Leaves, stems, crowns roots and seeds | Roots and crowns | Roots (growth chamber): roots were stabbed with a needle, and a piece of colonized stem with P. medicaginis was placed on non-wounded and wounded roots; Roots (greenhouse): Roots were wounded by abrasion with a file, then immediately immersed for 1 h in a spore suspension of 2 × 106 spores/mL; Crowns: crowns were inoculated by stabbing with a needle, then contaminated with spores | Roots (growth chamber): lesions in the wounded inoculated roots were longer than those in non-wounded inoculated roots; Roots (greenhouse): necrosis lesion Crowns: internal necrosis of the stem and upper taproot; extensive discoloration of the vascular tissues | [45] |
| America | Leaves | Leaves | Spraying spore suspension at 1.6 × 106 spores/mL | Chlorosis and spots | [40] |
| Leaves and stems | Leaves and stems | Spraying spore suspension | Lesions were apparent at 4 days postinoculation (dpi); At 12 dpi, many dark brown lesions with chlorotic halos were noted on leaves, occasionally killing entire trifoliate leaves and progressing approximately 1 cm down the stem | [52] | |
| Tunisia | Leaves and stems of M. truncatula | Leaves and roots | Leaves: spraying spore suspension at 1.0 × 106 spores/mL; Roots: conidia suspensions were depositing on roots (3 mm from the root apex) by using an in vitro inoculation method. | Leaves: necrosis and yellowing; Pycnidium production was observed on dead and dying foliar tissues; Roots: collar rot and brown discoloration; Pycnidium production was observed on collars and roots | [41] |
Disclaimer/Publisher’s Note: The statements, opinions and data contained in all publications are solely those of the individual author(s) and contributor(s) and not of MDPI and/or the editor(s). MDPI and/or the editor(s) disclaim responsibility for any injury to people or property resulting from any ideas, methods, instructions or products referred to in the content. |
© 2024 by the authors. Licensee MDPI, Basel, Switzerland. This article is an open access article distributed under the terms and conditions of the Creative Commons Attribution (CC BY) license (https://creativecommons.org/licenses/by/4.0/).
Share and Cite
Lan, Y.; Zhou, W.; Duan, T.; Li, Y.; Matthew, C.; Nan, Z. Alfalfa Spring Black Stem and Leaf Spot Disease Caused by Phoma medicaginis: Epidemic Occurrence and Impacts. Microorganisms 2024, 12, 1279. https://doi.org/10.3390/microorganisms12071279
Lan Y, Zhou W, Duan T, Li Y, Matthew C, Nan Z. Alfalfa Spring Black Stem and Leaf Spot Disease Caused by Phoma medicaginis: Epidemic Occurrence and Impacts. Microorganisms. 2024; 12(7):1279. https://doi.org/10.3390/microorganisms12071279
Chicago/Turabian StyleLan, Yanru, Wennan Zhou, Tingyu Duan, Yanzhong Li, Cory Matthew, and Zhibiao Nan. 2024. "Alfalfa Spring Black Stem and Leaf Spot Disease Caused by Phoma medicaginis: Epidemic Occurrence and Impacts" Microorganisms 12, no. 7: 1279. https://doi.org/10.3390/microorganisms12071279
APA StyleLan, Y., Zhou, W., Duan, T., Li, Y., Matthew, C., & Nan, Z. (2024). Alfalfa Spring Black Stem and Leaf Spot Disease Caused by Phoma medicaginis: Epidemic Occurrence and Impacts. Microorganisms, 12(7), 1279. https://doi.org/10.3390/microorganisms12071279

